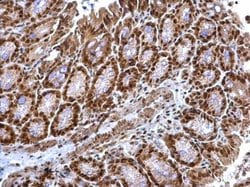
Invitrogen TRIP15 Polyclonal Antibody 100 &mu;L; Unconjugated:Antibodies,

Learn More
Invitrogen™ TRIP15 Polyclonal Antibody


Rabbit Polyclonal Antibody
Brand: Invitrogen™ PA530723
Description
Recommended positive controls: 293T, A431, HeLa, HepG7, NIH-3T3, JC, BCL-1. Predicted reactivity: Mouse (100%), Rat (100%), Zebrafish (99%), Xenopus laevis (97%), Pig (100%), Chicken (100%), Rhesus Monkey (100%), Bovine (97%). Store product as a concentrated solution. Centrifuge briefly prior to opening the vial.
Isocitrate dehydrogenases catalyze the oxidative decarboxylation of isocitrate to 2-oxoglutarate. These enzymes belong to two distinct subclasses, one of which utilizes NAD(+) as the electron acceptor and the other NADP(+). Five isocitrate dehydrogenases have been reported: three NAD(+)-dependent isocitrate dehydrogenases, which localize to the mitochondrial matrix, and two NADP(+)-dependent isocitrate dehydrogenases, one of which is mitochondrial and the other predominantly cytosolic. NAD(+)-dependent isocitrate dehydrogenases catalyze the allosterically regulated rate-limiting step of the tricarboxylic acid cycle. Each isozyme is a heterotetramer that is composed of two alpha subunits, one beta subunit, and one gamma subunit. The protein encoded by this gene is the beta subunit of one isozyme of NAD(+)-dependent isocitrate dehydrogenase. Three alternatively spliced transcript variants encoding different isoforms have been described for this gene.
Specifications
| TRIP15 | |
| Polyclonal | |
| Unconjugated | |
| COPS2 | |
| AI315723; ALIEN; alien homolog; Alien protein; alien-like; alien-PA; alien-PB; alien-PD; alien-PE; BcDNA:LD10463; beta-casein; C85265; CASB; casein beta; CG9556; CG9556-PA; CG9556-PB; CG9556-PD; CG9556-PE; CH2; COP9; COP9 (constitutive photomorphogenic) homolog, subunit 2; COP9 (constitutive photomorphogenic) homolog, subunit 2 (Arabidopsis thaliana); COP9 complex homolog subunit 2; COP9 constitutive photomorphogenic homolog subunit 2; COP9 signalosome complex subunit 2; COP9 signalosome subunit 2; COP9 signalosome subunit 2 CSN2; COPS2; Csn2; Csnb; d-Alien; DCH2; Dmel\CG9556; Dmel_CG9556; drosophila COP9 signalosome homolog 2; JAB1-containing signalosome subunit 2; SD08021p; SGN2; signalosome subunit 2; thyroid receptor interacting protein 15; thyroid receptor-interacting protein 15; TR-interacting protein 15; TRIP15; TRIP-15; tyroid receptor interacting protein 15 | |
| Rabbit | |
| Antigen affinity chromatography | |
| RUO | |
| 12848, 9318 | |
| Store at 4°C short term. For long term storage, store at -20°C, avoiding freeze/thaw cycles. | |
| Liquid |
| Immunohistochemistry (Paraffin), Western Blot, Immunocytochemistry | |
| 1 mg/mL | |
| PBS with 20% glycerol and 0.01% thimerosal; pH 7 | |
| P61201, P61202 | |
| COPS2 | |
| Recombinant protein encompassing a sequence within the center region of human TRIP15. The exact sequence is proprietary. | |
| 100 μL | |
| Primary | |
| Human, Mouse | |
| Antibody | |
| IgG |
Your input is important to us. Please complete this form to provide feedback related to the content on this product.